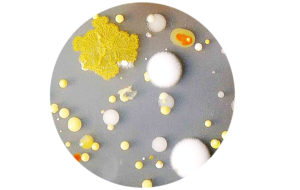

Mirco Goes Macro
Ein Zusammenhang auf den ich im Laufe meiner Recherche rund um das Thema Gefäße immer wieder gestoßen bin, war das Thema Leben und Tod. Die Vase symbolisiert den Anfang und das Ende in einer Welt, das Leben und der Tod wird hier in einer Form repräsentiert. Im kunsthistorischen Kontext repräsentiert die Vase zusammen mit anderen sehr symbolträchtigen Elementen, einerseits Reichtum, Luxus und Verschwendung, aber auch die damit verbundene Vergänglichkeit der Dinge bzw. des Lebens. In meinem Ansatz werden die Objekte nicht mehr nur als Symbol für etwas verstanden, sondern werden selbst zum Hauptakteur, die genau diese Lebendigkeit und gleichzeitige Vergänglichkeit verkörpern sollen. Ausgehend von diesen Überlegungen ist eine lebendige und somit auch vergängliche Objektreihe entstanden, die einen Gegenpol zu den perfekt präservierten und statischen Objekten im Kunstgewerbemuseum darstellen soll. Als Mittel der Lebendigkeit wurden Bakterien auf einem Agarnährboden und einer dreidimensionalen Form gezüchtet.
One connection I came across again and again in the course of my research on the subject of vessels was the theme of life and death. Life and death are represented here in one form of an object. In the context of art history, the vase, together with other very symbolic elements, represents on the one hand wealth and luxury, but also the associated transience of life. In my approach, the objects are no longer understood as a symbol of something, but become the main actor themselves, which are supposed to embody exactly this liveliness and simultaneous transience. Based on these considerations, a living and therefore also transient series of objects were created. This should also be a counterpart to the perfectly preserved and static objects in the Kunstgewerbemuseum. As a tool for liveliness, bacteria were grown on an agar soil and a three-dimensional form.
Prozess